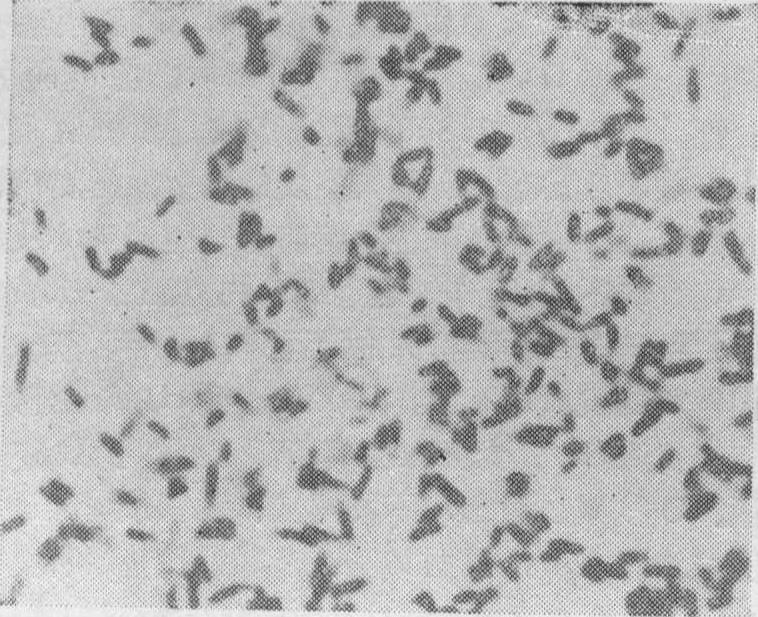

大肠杆菌Escherichia coli
栖居在温血动物肠道中的革兰阴性杆菌。0.4~0.7μm×1.0~3.0μm,单个或成对。许多菌株具有多糖荚膜。靠周生鞭毛运动,有的不形成鞭毛。某些菌株表面着生有大量菌毛。菌落呈半透明露滴状,表面闪光。
化能有机营养型,兼性厌气,最适生长温度37℃。氧化酶阴性。通常利用醋酸盐,而不利用柠檬酸盐作为碳源。发酵葡萄糖、乳糖和其他碳水化合物,产生乳酸、醋酸和甲酸。一部分甲酸被复合的甲酸脱氢酶系统裂解成等量的CO2和H2。能合成人体需要的维生素B和维生素K。有些菌株还能分泌大肠菌素(见细菌素)。
大肠杆菌一般不致病,但当它转移至非正常定居部位时,即可致病。如肾炎、膀胱炎等泌尿道感染,某些菌型能产生肠毒素,可引起婴儿和幼畜的严重腹泻。常作为检查饮水卫生标准的指示菌。
大肠杆菌是微生物学基础研究的重要材料。首先报道的细菌基因重组是大肠杆菌的K12菌株,最早发现的细菌质粒是大肠杆菌的致育因子(即F因子)。近年来在分子遗传学和遗传工程方面,对大肠杆菌的研究更加深入和广泛。
大肠杆菌
Escherichia coli Castellani et Chalmers,又称大肠埃希氏杆菌。肠杆菌科(Enterobacteriaceae)。栖居在人和温血动物肠道中的革兰氏阴性短杆菌,1.1 ~1.5μm×2.0~6.0μm(活菌);0.4~0.7μm×1.0~3.0μm(干燥染色),单个或成对。菌落白色至黄白色,表面闪光,许多菌株具有多糖荚膜,靠周身鞭毛运动,无芽胞。最适生长温度30~37℃。能使牛奶迅速产酸凝固,不胨化。明胶不液化。产生吲哚,甲基红阳性,V.P.阴性,不利用柠檬酸盐。通常利用醋酸盐,发酵葡萄糖、乳糖和其他碳水化合物。产生乳酸、醋酸和甲酸。DNA中G+C的mol数为0.50~0.51。大肠杆菌一般不致病,是人和动物肠道中最主要的和数量最多的一种细菌,寄生于大肠内。当它转移至非正常定居部位时,即可导致疾病,如肾炎、膀胱炎等泌尿道感染。某些菌型能产生肠毒素,可引起婴儿和幼畜的严重腹泻。该种某些菌株可用于测定精氨酸、天门冬氨酸、维生素B12或用于产生精氨酸、谷氨酸脱羧酶及大肠菌素,也是遗传学研究的重要实验材料。
大肠杆菌dachangganjunEscherichia coli
细菌门。细胞杆状,直径约1微米,长约2微米,两端钝圆,周身具鞭毛,可运动。革兰氏染色阴性,不形成芽孢。菌落圆形,白色或黄白色,光滑而具闪光,低平或微凸起,边缘整齐。最适条件下培养20分钟可繁殖1代。大肠杆菌是人和温血动物肠道内普遍存在的细菌,是粪便中的主要菌种。一般生活在人大肠中并不致病,可能在肠中对合成维生素K起作用。但偶尔侵入到阑尾、胆囊、腹腔或泌尿系统时,可发生炎症。大肠杆菌在工业上,可用以制备L-门冬酰胺酶,此酶是治疗白血病效果较好的一种药物。还可利用它的谷氨酸脱羧酶来测定谷氨酸含量。在科研上是生物化学、遗传学和分子生物学的适合的材料。此外,在水质监测方面,根据其有无及其数量多少,可作为检测水质状况和污染程度的重要指标。
大肠杆菌
肠道杆菌的一种。人和动物肠道中最多见的正常菌群。革兰氏阴性短杆菌,两端钝圆,无芽孢,能运动,初生儿或动物出生后数小时即进入肠道。除某些血清型能致人类尤其是婴儿腹泻外,一般不致病;能合成维生素K和B,对人体有利;偶引发肠道外感染,如泌尿道感染,腹膜炎等。因在粪便中数量极多,常用作检查水源是否受粪便污染的标志。
大肠杆菌colibacillus,escherichia coli
是一种革兰阴性细菌。系埃希菌属。是人和动物肠道中最主要的、数量最多的细菌。其两端钝圆,能运动,为无芽胞的短杆菌。在普通培养基上生长良好。它能迅速分解葡萄糖、乳糖、麦芽糖等,产酸、产气。一般不致病。能合成维生素B和维生素K,并产生大肠菌素抑制肠道致病菌(如痢疾杆菌)和腐生菌的繁殖。但侵入其他组织和器官,可引起化脓性炎症,如肾盂肾炎、腹膜炎、胆囊炎等;侵入血液可引起败血症。对磺胺药、链霉素和四环素族药物均敏感。
大肠杆菌
大肠杆菌 (Escherichia coli)是艾氏菌属中唯一菌种(见图)。大多数菌株有动力。有菌毛,包括性菌毛。有些有多糖类荚膜或包膜,在普通培养基上菌落直径2~3mm。在血平板上,有些菌株有乙型溶血环。生长温度范围为15~44℃,最适温度37℃。能发酵乳糖、葡萄糖和甘露醇,产酸产气。对蔗糖的发酵因菌种而异。与其他肠道中发酵乳糖菌种的区别见表1。
表1 大肠杆菌与其他乳糖发酵菌的鉴别
| 菌 名 | 动 力 | 葡 萄 糖 | 乳 糖 | 麦 芽 糖 | 甘 露 醇 | 蔗 糖 | 硫 化 氢 | 尿 素 | 吲 哚 | 甲 基 红 | V P | 枸 橼 酸 盐 | 苯脱 丙氨 氨酶 酸 | 赖脱 氨羧 酸酶 | 鸟脱 氨羧 酸酶 |
| 大肠杆菌 产气杆菌 肺炎杆菌 阴沟杆菌 沙雷杆菌 | + + - + + | ⊕ ⊕ ⊕ ⊕ + | ⊕ ⊕/L ⊕/- ⊕/- ± | ⊕ ⊕ ⊕ ⊕ + | ⊕ ⊕ ⊕ ⊕ + | -/⊕ ⊕/- ⊕ ⊕ + | - + - - - | - - ± ± - | + - - - - | + - - - - | - + + + + | - + + + + | - - - - - | +/- - + - + | +/- +/- - + + |
L: 迟缓阳性 +: 阳性或产酸  : 产酸产气
: 产酸产气
大肠杆菌 ×1300
大肠杆菌有O、H、K、菌毛和共同抗原(EAC),前三种常用于分型。目前已知有160种O抗原,至少90种K抗原和50种H抗原。O抗原是分群的基础,但一种O抗原并不等于一个血清型,同时还要结合K和H抗原的型别。K抗原按不同性质尚可分为L、A和B三种。在一个菌株中,K抗原仅有其中一种。大肠杆菌的型别按O∶K∶H排列,如O111∶58∶2。K抗原存在时,细菌在抗O血清中不凝集,需先加热去除K抗原。本菌在自然界生存力较强,在土壤与水中可活数月,冷藏条件下生存更久。对青霉素中度敏感,对磺胺类、链霉素、氯霉素、金霉素等均敏感,但目前耐药菌株很多,有些耐药性是通过质粒从其他耐药性肠道杆菌转移获得的。胆盐、亚硝酸盐、煌绿染料等对本菌有选择性抑制作用,已被用于制备选择培养基。
引起的人类疾病可有肠道感染与肠道外感染。
(1) 肠道感染: 引起腹泻的大肠杆菌可分为三组,即肠中毒型大肠杆菌、肠致病型大肠杆菌与肠侵袭型大肠杆菌(表2)。
❶肠中毒型大肠杆菌: 是儿童腹泻和旅游者腹泻中最常见病菌。其特点是能产生肠毒素。肠毒素有不耐热 (LT),与耐热 (ST) 两种。有些菌株仅产生一种,有些则产生两种。肠毒素的产生与否由质粒控制。LT可能是蛋白质,65℃30分钟被破坏。与霍乱弧菌的肠毒素相关,二者的抗血清有交叉中和作用。ST的分子量较小,无免疫原性,能耐受100℃,10~20分钟而不被灭活。最敏感的检测毒素的方法是对YI小鼠肾上腺细胞或中国地鼠卵巢细胞培养的毒性作用。检测ST多用幼鼠胃内灌注法。除肠毒素外,菌毛可能也有重要致病作用。菌毛有抗原性,动物实验中证实相应抗血清有潜在保护作用。对人类致病的关系尚在研究中。细菌在小肠中生长,不损害上皮细胞,所产生的肠毒素刺激小肠上皮细胞的腺苷酸环化酶,提高其活性,使胞内的cAMP上升,引起急性脱水和电解质异常,导致腹泻,与霍乱相似,但症状较轻。
❷肠致病型大肠杆菌: 不产生肠毒素。致病因子不详,主要引起婴儿腹泻。成人多为带菌者,表明人在幼年时接触细菌后已获得免疫。细菌定位于十二指肠、空肠和回肠上端。大鼠空肠的灌注实验中,发现病菌能吸引液体进入肠腔。
❸肠侵袭型大肠杆菌: 于1967年在日本首先分离。菌大多无动力。常不发酵或迟发酵乳糖。若干菌型的抗原与某些痢疾杆菌有交叉。发生在较大儿童与成人中。可引起暴发性流行或散发型病例。对豚鼠作滴眼试验能引起结膜角膜炎(Sereny试验),可用于检测其侵袭力。不产生肠毒素,但能侵袭大肠壁的上皮细胞,破坏基底膜细胞,引起炎症与溃疡。
表2 人类肠道感染中的致病性大肠杆菌血清型
(WHO,1979)
| 肠中毒型 (27个血清型) | 06:K15:H16 07:H18 08:K40:H9 08:K47 08:K25:H9 09:K84:H2 015:H11 020:K+ 025:K7:H42 025:K98 | B27:H7 027:H20 063:H12 073:H45 078:H12 078:H11 0114:H21 0115:H51 0128:H7 0128:H12 | 0128:H21 0148:H28 0153:H12 0153:H10 0159:H4 0159:H34 OX2:H41 |
| 肠致病型 (17个O血清型) 肠侵袭型 (8个O型) | 18,20,25,26,28,44,55,86,111,112, 114,119,125,126,127,128,142 28ac,112ac,124,136,143,144, 152, 168 | ||
(2) 肠道外感染: 引起肠道外感染的菌多有K抗原,抗吞噬和补体的杀菌作用,有较强侵袭力。是泌尿道感染中最常见细菌。也可引起败血症、新生儿脑膜炎、手术后伤口感染和机体不同部位的脓肿。
微生物学检查采取中段尿、血液、脑脊髓液、脓汁、粪便等。先分离出细菌,然后用生化反应鉴定。来自粪便中的致病性大肠杆菌,需用血清学试验加以O、K抗原定型。尿路感染除确定其为大肠杆菌外,还应检测细菌的数量,仅每当1ml尿含量≥100,000时,才有诊断价值。水、食品、饮料的卫生学检查常以大肠杆菌指数作为粪便污染指标。检查方法包括:
❶每g食品或ml水中细菌的总数和;
❷大肠菌群检查 (指在37℃培养24小时时能发酵乳糖,产酸与气)。我国的卫生标准是每ml饮水中细菌总数不得超过100个,每1,000ml水中不超过3个大肠菌群; 瓶装汽水、果汁等每ml细菌总数不超过100个,每100ml中大肠菌群不超过5个。本菌对磺胺类和抗生素敏感,但近年来抗多种药物菌株不断增加。因此,在用药前,应做药物敏感试验,以便选用适合药品提高疗效。
大肠杆菌
colibacillus;Escherichia coli(E.coli)
- 𢅼是什么意思
- 𢅾是什么意思
- 𢆉是什么意思
- 𢆓是什么意思
- 𢆚是什么意思
- 𢆞是什么意思
- 𢆞麻是什么意思
- 𢆡是什么意思
- 𢆡扽扽是什么意思
- 𢆡𠆶𠆶是什么意思
- 𢆩是什么意思
- 𢆯是什么意思
- 𢆴是什么意思
- 𢆶是什么意思
- 𢆶部是什么意思
- 𢆷是什么意思
- 𢆷孙是什么意思
- 𢆸是什么意思
- 𢆻是什么意思
- 𢆽是什么意思
- 𢆿是什么意思
- 𢇇是什么意思
- 𢇍是什么意思
- 𢇗是什么意思
- 𢇘是什么意思
- 𢇙是什么意思
- 𢇚是什么意思
- 𢇛是什么意思
- 𢇞是什么意思
- 𢇤是什么意思
- 𢇦是什么意思
- 𢇧是什么意思
- 𢇲是什么意思
- 𢇳是什么意思
- 𢇴是什么意思
- 𢇶是什么意思
- 𢇷是什么意思
- 𢇸是什么意思
- 𢈈是什么意思
- 𢈉是什么意思
- 𢈉仔是什么意思
- 𢈉仔只是什么意思
- 𢈉仔唇是什么意思
- 𢈉仔墘是什么意思
- 𢈉仔枝是什么意思
- 𢈉仔空是什么意思
- 𢈉盘是什么意思
- 𢈕是什么意思
- 𢈚是什么意思
- 𢈜是什么意思
- 𢈝是什么意思
- 𢈠是什么意思
- 𢈢是什么意思
- 𢈪是什么意思
- 𢈪亭是什么意思
- 𢈪亭銘是什么意思
- 𢈪堂是什么意思
- 𢈪堂乐府是什么意思
- 𢈪堂集是什么意思
- 𢈵是什么意思